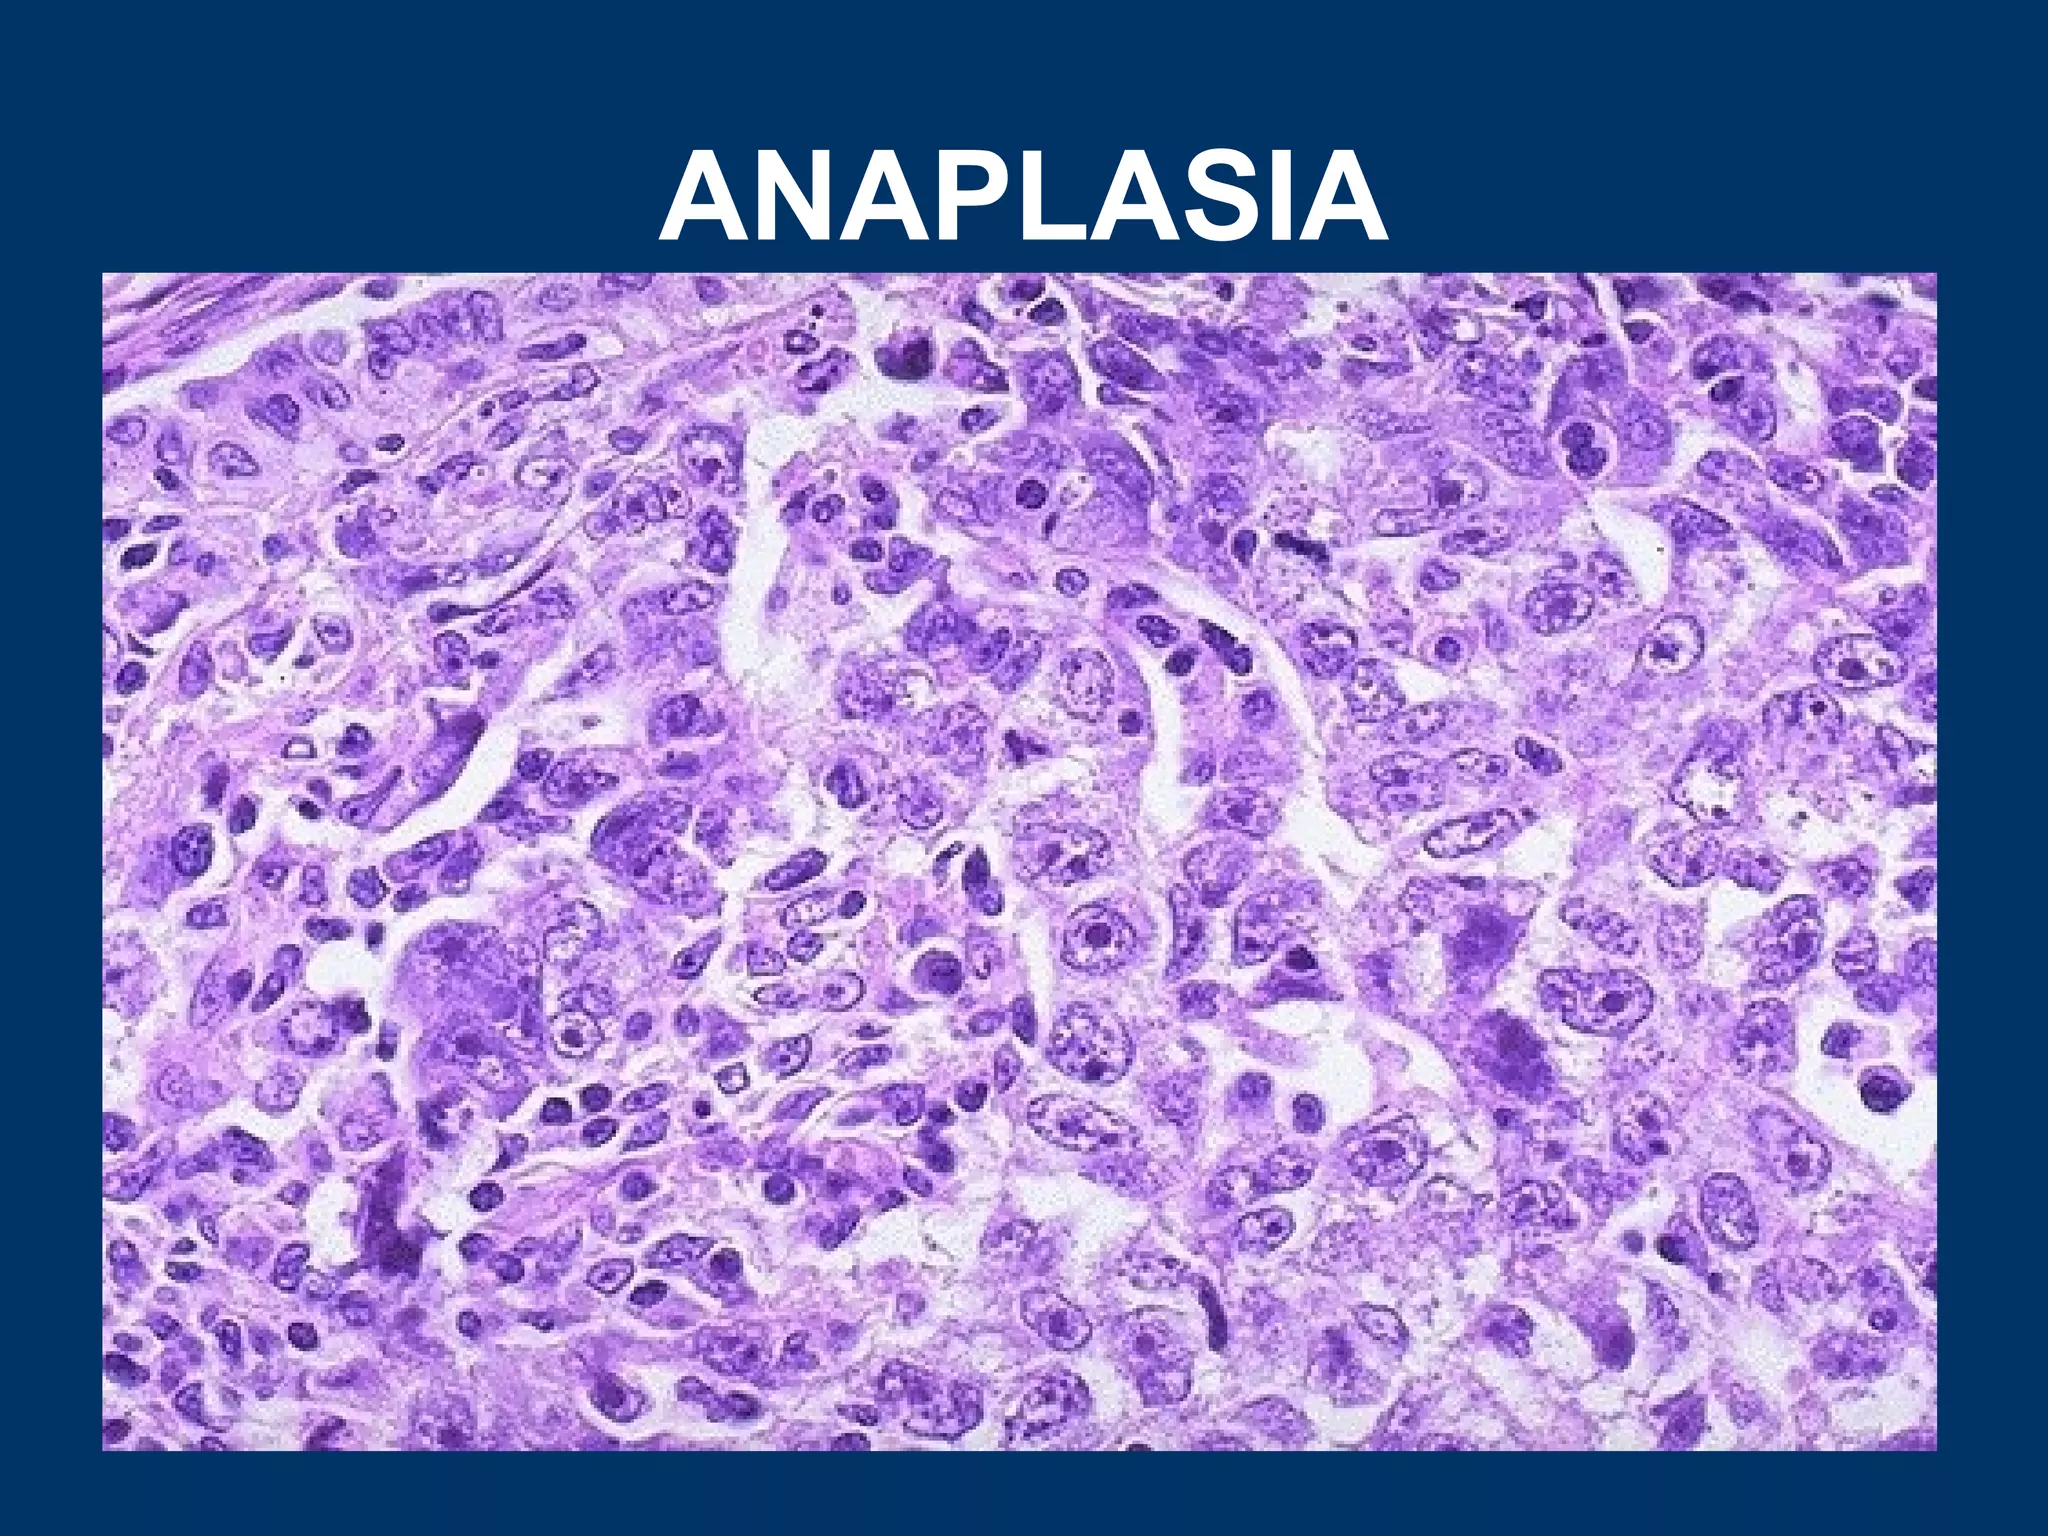
ANAPLASIA

Cellular adaptations can occur through hyperplasia, hypertrophy, atrophy, or metaplasia in response to stress or changes in workload or stimulation. Hyperplasia involves an increased number of cells through cell proliferation. Hypertrophy involves cellular enlargement without an increase in cell number. Atrophy is a decrease in cell size. Metaplasia is the replacement of one adult cell type with another. Examples provided include uterine hyperplasia during pregnancy, cardiac hypertrophy in hypertension, muscle fiber atrophy after injury or disuse, and squamous metaplasia in the lungs of smokers. Dysplasia refers to alterations in cell size, shape, and organization and is a pre-cancerous condition.